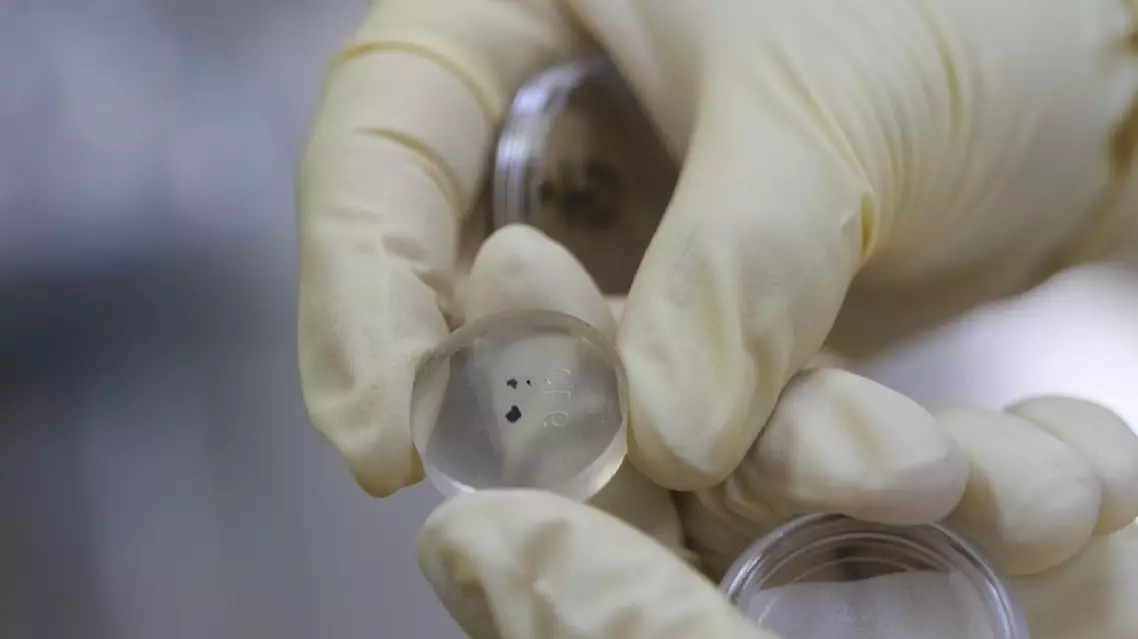

A Chinese researcher involved in the study of Chang'e-6's far-side lunar samples has outlined an approach of three-step research into the lunar samples, including the preparation of target samples, microscopic observation and further data analysis, in efforts to fully utilize the valuable resources brought back by China's landmark 2024 lunar probe mission.
Research has been underway since the Chang'e-6 mission in 2024, which marked humanity's first successful lunar sample retrieval from the far side of the moon, recovering 1,935.3 grams of materials from the Apollo Basin within the South Pole-Aitken (SPA) Basin.
The far-side lunar studies have reached a significant milestone, as a joint research team organized by the China National Space Administration (CNSA) verified the hypothesis that the moon was entirely covered by a molten "magma ocean" in the early stages after its birth, providing critical evidence for understanding the moon's origin and evolution.
The research team from the Institute of Geology, the Chinese Academy of Geological Sciences was granted two grams of Chang'e-6 samples for their research.
In an interview with China Central Television, Che Xiaochao, an associate researcher at the Research Center for Planetary Science of the Institute, talked about the three key steps in their research of the precious lunar samples, with the first step involving processing the samples into standard targets suitable for observation and analysis.
"This is the laboratory where we store lunar samples, with the glovebox filled with high-purity nitrogen to keep the moon soil dry and free from oxygen. The Chang'e-6 lunar samples are very fine-grained, and our first task is to select 33 grains, namely 33 basalt fragments each measuring larger than 500 microns in diameter, from the two grams of lunar samples, and make them into a standard target that can be put into our instruments," Che explained.
Once the appropriate samples were selected, the next step is to use microscopic equipment to observe their physical and chemical properties, according to Che.
"As you can see, this is the position for holding a standard target we have made with basalt grains separated from the Chang'e-6 lunar samples. Let me open it and you can take a look. The holder is made from resin, on which two grains separated from the Chang'e-6 lunar samples have been stuck. We will put it into this instrument for microscopic observation. This electron image shows the distribution of the elements of the grains: yellow for calcium, green for magnesium and purple for iron. By analyzing these colors and brightness, we can reconstruct its mineral composition," Che noted.
The final and most important step is to extract deeper information about the far-side moon's samples, including their age and isotopic composition.
"We use this instrument, a Secondary Ion Mass Spectrometer (SIMS), to date the samples. Through this process, we can determine the age of the basalt present in the Chang'e-6 samples to be 2.823 billion years. By analyzing the lead isotope composition and combining it with previous studies of lunar samples from the near side, we have inferred the existence of a magma ocean on the moon's far side," Che stated.
Moving forward, the CNSA will continue to advance lunar sample research and share scientific findings with the rest of the international community, according to Che.

Researcher outlines key steps in Chang'e-6 far-side lunar samples study

Researcher outlines key steps in Chang'e-6 far-side lunar samples study
Researcher outlines key steps in Chang'e-6 far-side lunar samples study









